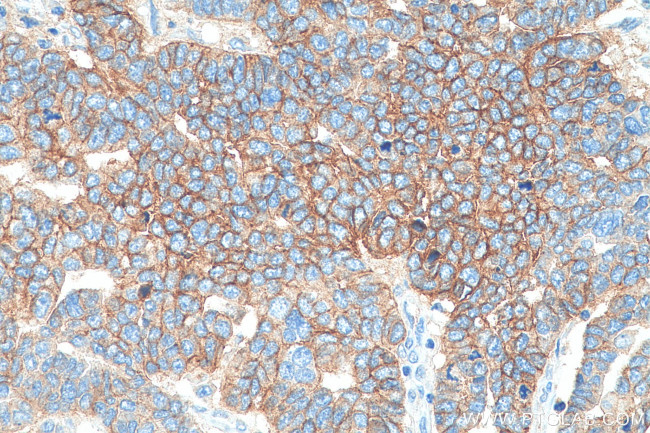
CD9 Antibody in Immunohistochemistry (Paraffin) (IHC (P))

Search
Proteintech
CD9 Monoclonal Antibody (4H7B9), Biotin Plus
{{$productOrderCtrl.translations['antibody.pdp.commerceCard.promotion.promotions']}}
{{$productOrderCtrl.translations['antibody.pdp.commerceCard.promotion.viewpromo']}}
{{$productOrderCtrl.translations['antibody.pdp.commerceCard.promotion.promocode']}}: {{promo.promoCode}} {{promo.promoTitle}} {{promo.promoDescription}}. {{$productOrderCtrl.translations['antibody.pdp.commerceCard.promotion.learnmore']}}
产品信息
BIOTIN-60232
种属反应
宿主/亚型
分类
类型
克隆号
抗原
偶联物
形式
纯化类型
保存液
内含物
保存条件
运输条件
产品详细信息
Immunogen sequence: FAIEIAAAIW GYSHKDEVIK EVQEFYKDTY NKLKTKDEPQ RETLKAIHYA LNCCGLAGGV EQFISDICPK KDVLETFTVK SCPDAIKEVF DNKFHIIGAV GIGIAVVMI
靶标信息
CD9 antigen is a glycoprotein expressed on the surface of developing B lymphocytes, platelets, monocytes, eosinophils, basophil, stimulated T lymphocytes and by neurons and glial cells in the peripheral nervous system. CD9 belongs to a family of membrane proteins termed tetraspanins which transverse the membrane four times. In pre B cells and platelets, CD9 antigen regulates cell activation and aggregation possibly through an association with the integrin CD41 / CD61 (GPIIb / GPIIIa). CD9 is involved in cell motility, osteoclastogenesis, neurite outgrowth, myotube formation, and sperm-egg fusion, plays roles in cell attachment and proliferation and is necessary for association of heterologous MHC II molecules on the dendritic cell plasma membrane which is important for effective T cell stimulation. CD9 functions in many cellular processes including differentiation, adhesion, and signal transduction, and expression plays a critical role in the suppression of cancer cell motility and metastasis. CD9 is also considered as metastasis suppressor in solid tumors.
仅用于科研。不用于诊断过程。未经明确授权不得转售。
篇参考文献 (0)
生物信息学
蛋白别名: 5H9; 5H9 antigen; antigen CD9; BA-2/p24 antigen; BA2; BTCC-1p; CD9; CD9 antigen; CD9 antigen (p24); Cell growth-inhibiting gene 2 protein; GIG2; Leukocyte antigen MIC3; motility related protein-1; Motility-related protein; MRP-1; p24; sCD 9; sCD9; soluble CD 9; soluble CD9; Tetraspanin-29; Tetraspanin29; Tspan-29; unnamed protein product
基因别名: BTCC-1; CD9; DRAP-27; GIG2; MIC3; MRP-1; TSPAN-29; TSPAN29
UniProt ID: (Human) P21926
Entrez Gene ID: (Human) 928